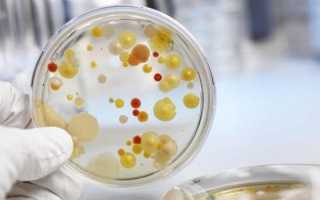
Диагностика вирусного гепатита С — первые признаки и проявления

По данным статистики, 2% населения России заражены гепатитом С. Зачастую бессимптомное развитие заболевания делает его диагностику и лечение затруднительным. Анализы, МРТ, КТ, биопсия укажут на наличие болезни.
Особенности течения болезни
Возбудитель патологии − РНК-содержащий вирус семейства Flaviviridae. Болезнетворный вирус представляет опасность вследствие длительного пребывания в организме человека без выраженных признаков. Путь заражения − трансфузионный или парентеральный (через кровь), но возможно инфицирование и через слюну, сперму или мочу.
Нередко заражение происходит при использовании нестерильного инструмента во время маникюра, нанесения татуировки, стоматологических манипуляций. 80% людей, которые регулярно принимают наркотики, инфицированы. Инкубационный период составляет до 26 недель.
Преобладает бессимптомное хроническое течение заболевания, редко наблюдается среднетяжелое развитие. Из-за этого патология сложно поддается диагностике, нередко приводит к серьезным осложнениям, таким как цирроз (риск развития составляет 20%) или гепатоцеллюлярный рак печени (риск развития составляет 2%). При употреблении алкоголя вероятность возникновения осложнений значительно возрастает.
Статьи по теме
- Носительство гепатита В – что это значит, поведение, профилактические меры и диета
- Профилактика гепатита A у детей и взрослых – меры предотвращения заражения вирусом
- Профилактика вирусного гепатита В у детей и взрослых – как избежать заражения

Мнение врача:
Диагностика вирусного гепатита C является важным этапом в выявлении заболевания. Первые признаки и проявления могут быть незаметны, что затрудняет своевременную диагностику. Врачи отмечают, что основными симптомами гепатита C могут быть усталость, потеря аппетита, тошнота, боли в животе, желтуха. Однако у некоторых пациентов заболевание может протекать бессимптомно в течение длительного времени. Поэтому важно обратиться к врачу при любых подозрительных симптомах или после возможного контакта с инфицированным материалом. Ранняя диагностика позволяет начать лечение на ранней стадии и предотвратить развитие осложнений.

Как выявить вирусный гепатит С
Диагностика заключается в определении вирусной нагрузки (методом полимеразной цепной реакции − ПЦР) и количества антител к возбудителю (скрининг). Вирусные частицы способны мутировать, что еще больше осложняет их выявление. Способы диагностики:
- Лабораторные методы. Они информативны, поскольку дают максимум данных о состоянии крови больного.
- Инструментальные способы исследования. Эти менее эффективны, дают представление о состоянии печени, но не раскрывают причины.
Лабораторные методы диагностики
Анализы при гепатите С показывают вирусную нагрузку (количество вирусов в титре крови) и наличие антител к болезнетворному возбудителю. В отношении гепатита С эффективны:
- общая кровь, биохимический анализ;
- антитела к гепатиту С;
- определение количества вирусных частиц.
Анализы рекомендовано сдавать дважды во избежание ложноположительных и ложноотрицательных результатов.
Инструментальные
Испытания с применением инструментальных методов дают информацию о структуре печени:
- магнитно-резонансная томография (МРТ);
- компьютерная томография (КТ);
- ультразвуковое исследование (УЗИ);
- биопсия печени.

Интересные факты
-
Инфицирование гепатитом C обычно происходит бессимптомно, особенно на ранней стадии, известной как острый гепатит С.
-
Диагностика гепатита С часто включает анализ крови на антитела к вирусу гепатита С (ВГС) и тест на вирусную нагрузку.
-
Вакцины против гепатита С не существует, но существуют эффективные противовирусные препараты, способные вылечить большинство случаев гепатита С.

Правила сдачи анализов
Для достоверности результата при проведении анализов необходимо придерживаться некоторых правил:
- Кровь нужно сдавать натощак.
- За день до проведения исследования рекомендуется воздержаться от цитрусовых и овощей (особенно от оранжевых).
- Лекарства с утра рекомендуется не принимать, лучше взять их с собой и выпить после проведения анализов.
Опыт других людей
Диагностика вирусного гепатита C играет важную роль в своевременном выявлении заболевания. Люди, обращающиеся за медицинской помощью, отмечают, что первые признаки гепатита C могут быть незаметными. Однако, при появлении усталости, потери аппетита, болей в животе или изменении цвета мочи, стоит обратить внимание на состояние своего здоровья. Раннее обследование и выявление вируса помогут предотвратить развитие серьезных осложнений.
Видео
Внимание!
Информация, представленная в статье, носит ознакомительный характер. Материалы статьи не призывают к самостоятельному лечению. Только квалифицированный врач может поставить диагноз и дать рекомендации по лечению, исходя из индивидуальных особенностей конкретного пациента.
Частые вопросы
Когда появляются первые признаки гепатита С?
Симптомы острого гепатита С включают желтуху, усталость, тошноту, жар и мышечные боли. Они появляются через 1-3 месяца после инфицирования вирусом и продолжаются от двух недель до трех месяцев. Острая инфекция гепатита С не всегда переходит в хроническую фазу.
Как выявить гепатит С на ранних стадиях?
ПЦР-тест на РНК вируса гепатита С назначают при положительном анализе на антитела. Он позволяет выяснить, активно ли заболевание в настоящее время. Отрицательный результат означает, что заражение гепатитом С было в прошлом, но организм справился с инфекцией.
Какие симптомы при гепатите С?
Симптомы могут включать высокую температуру, утомляемость, потерю аппетита, тошноту, рвоту, боли в брюшной полости, потемнение мочи и пожелтение кожных покровов и склер глаз (желтуху). Вакцины от гепатита С не существует, но его можно лечить противовирусными препаратами.
Как точно определить гепатит С?
Для определения в крови вируса гепатита С необходимо сдать анализ на антитела Anti-HCV, который показывает был ли когда-либо контакт с вирусом. Стоимость анализа 550 руб.
Полезные советы
СОВЕТ №1
Если у вас есть подозрения на наличие вирусного гепатита C, обратитесь к врачу для проведения специальных тестов и диагностики. Не откладывайте визит к врачу, так как раннее обнаружение инфекции может помочь в своевременном начале лечения.
СОВЕТ №2
Избегайте контакта с кровью других людей, чтобы предотвратить возможную передачу вируса. Это включает в себя использование индивидуальных предметов гигиены (например, зубных щеток, бритв и т.д.) и предостережение от использования общих инъекционных шприцев.
СОВЕТ №3
Следите за своим образом жизни и избегайте поведения, которое может повысить риск заражения вирусом гепатита C, такого как употребление наркотиков через инъекции или небезопасный сексуальный контакт. Помните, что профилактика играет важную роль в предотвращении распространения инфекции.